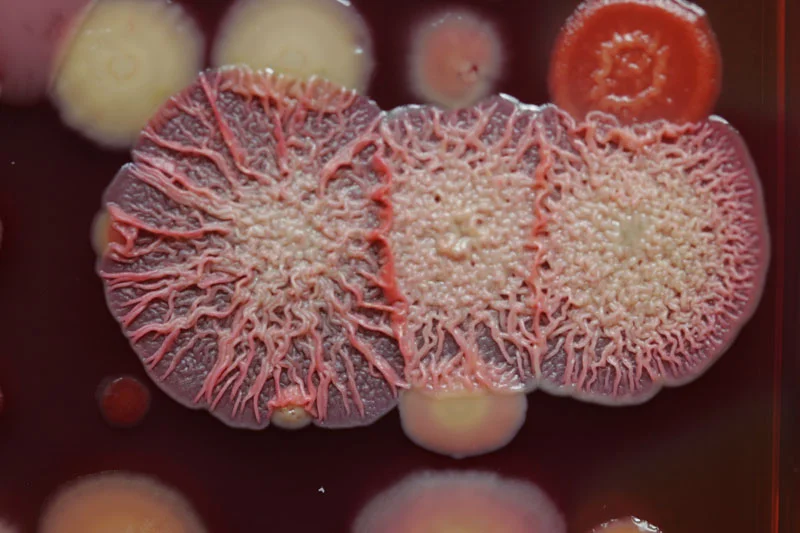
22.jpg

Publications
Whitney Lab trainees in bold
2026
Shah PY*, Garrett SR*, Klein TA, Pfoh R, Raphenya AR, McArthur AG, Howell PL, Whitney JC (2026) EsxA is required for antibacterial toxin export by the type VIIb secretion system. J Biol Chem 113240. *Equal contribution.
Paracuellos P, Bexter A, Patkowski JB, Kelly SD, Omelchenko O, Macé K, Ilangovan A, Subramoni S, Whitney JC, Filloux A, Costa TRD (2026) Molecular basis of type VI secretion system effector loading. Nature Microbiology [online ahead of print].
Van Schepdael M, Asakereh I, Colautti J, Gierys AJ, Sachar K, Ahmad S, Khajehpour M, Whitney JC, Prehna G (2026) Biophysical characterization of Eag chaperones suggests the mechanism of effector transmembrane domain release. Nature Communications 17:1401.
2025
Ahmad S, Guedez AG, Manisa B, Adewale A, Tsang KK, Schiefer V, Bullen NP, Thakar H, Kim Y, Wang B, Whitney JC (2025) Bacteria export alarmone synthetases that produce (p)ppApp and (p)ppGpp. mBio 16, e0222725.
Colautti J, Garrett SR, Whitney JC (2025) Proteolytically activated antibacterial toxins inhibit the growth of diverse Gram-positive bacteria. Proc Natl Acad Sci USA 122, e2505807122.
Colautti J, Shatskiy D, Bates E, Bullen NP, Belyy A, Whitney JC (2025) Cryo-EM structure of a type VI secretion system delivered membrane-depolarizing toxin involved in bacterial antagonism. Cell Reports 44, 116263.
Gkragkopoulou P, Garrett SR, Shah PY, Grebenc DW, Klein TA, Kim Y, Whitney JC (2025) A widespread family of molecular chaperones promotes the intracellular stability of type VIIb secretion system-exported toxins. Proc Natl Acad Sci USA 122, e2503581122.
Evans SL, Peretiazhko I, Karnani SY, Marmont LS, Wheeler JH, Tseng BS, Durham WM, Whitney JC, Bergeron JR (2025) The structure of the Tad pilus alignment complex reveals a periplasmic conduit for pilus extension. Nature Communications 16:6977.
Colautti J, Kim Y, Whitney JC (2025) Antibacterial ADP-ribosyl cyclase toxins inhibit bacterial growth by rapidly depleting NAD(P)+. J Biol Chem 110491.
Lv F, Alexei AG, Colautti J, Bullen NP, Whitney JC (2025) Molecular determinants of nucleic acid recognition by an RNA-targeting ADP-ribosyltransferase toxin. J Biol Chem 110463.
Azhieh A, Hernandez P, Anderson AC, Sychantha D, Verster AJ, Whitney JC#, Ross BD# (2025) Rapidly evolving orphan immunity genes protect human gut bacteria from intoxication by the type VI secretion system. BioRxiv doi.org/10.1101/2025.05.03.651265. #co-corresponding authors.
Lu Y*, Schuller M*, Bullen NP*, Mikolcevic P, Zonjic I, Raggiaschi R, Mikoc A, Whitney JC#, Ahel I# (2025) Discovery of reversing enzymes for RNA ADP-ribosylation reveals a possible defence module against toxic attack. Nucleic Acids Res 53, gkaf069. *Equal contribution. #co-corresponding authors.
Sachar K, Kanarek K, Colautti J, Kim Y, Bosis E, Prehna G, Salomon D, Whitney JC (2025) A conserved chaperone protein is required for the formation of a non-canonical type VI secretion system spike tip complex. J Biol Chem 301, 108242.
Colautti J, Kelly SD, Whitney JC (2025) Specialized killing across the domains of life by the type VI secretion systems of Pseudomonas aeruginosa. Biochem J 482: 1–15.
2024
Alexei AG, Bullen NP, Garrett SR, Sychantha D, Whitney JC (2024) The antibacterial activity of a prophage-encoded fitness factor is neutralized by two cognate immunity proteins. J Biol Chem 300, 108007.
Colautti J, Tan H, Bullen NP, Thang SS, Hackenberger D, Doxey AC, Whitney JC (2024) A widespread accessory protein family diversifies the effector repertoire of the type VI secretion system spike. Nature Communications 15:10108.
Bullen NP*, Johnson CN*, Andersen SE, Arya G, Marotta SR, Whitney JC#, Duerkop BA# (2024) An enterococcal phage protein inhibits type IV restriction enzymes involved in antiphage defense. Nature Communications 15:6955. *Equal contribution. #co-corresponding authors.
Klein TA*, Shah PY*, Gkragkopoulou P, Grebenc DW, Kim Y, Whitney JC (2024) Structure of a tripartite protein complex that targets toxins to the type VII secretion system. Proc Natl Acad Sci USA 121, e2312455121. *Equal contribution.
Argonne National Laboratory Press Release
2023
González-Magaña A, Tascón I, Altuna-Alvarez J, Queralt-Martín M, Colautti J, Velázquez C, Zabala M, Rojas-Palomino J, Cárdenas M, Alcaraz A, Whitney JC, Ubarretxena-Belandia I, Albesa-Jové D (2023) Structural and functional insights into the delivery of a bacterial Rhs pore-forming toxin to the membrane. Nature Communications 14, 7808.
Ahmad S, Whitney JC (2023) Location, location, location: an antidote that both activates and neutralizes a toxin used in bacterial warfare. J Bacteriol 205(6):e0016123.
Ahmad S, Gordon IJ*, Tsang KK*, Alexei AG*, Sychantha D, Colautti J, Trilesky SL, Kim Y, Wang B, Whitney JC (2023) Identification of a broadly conserved family of enzymes that hydrolyse (p)ppApp. Proc Natl Acad Sci USA 120, e2213771120. *Equal contribution.
Colautti J, Bullen NP, Whitney JC (2023) Lack of evidence that Pseudomonas aeruginosa AmpDh3-PA0808 constitute a type VI secretion system effector-immunity pair. Mol Microbiol 119, 262-274.
2022
Bullen NP, Sychantha D, Thang SS, Culviner PH, Rudzite M, Ahmad S, Shah VS, Filloux A, Prehna G, Whitney JC (2022) An ADP-ribosyltransferase toxin kills bacterial cells by modifying structured non-coding RNAs. Molecular Cell 82, 3484-3498.
Highlighted by ASBMB Today and Genetic Engineering & Biotechnology News
Written up in the Hamilton Spectator
Klein TA, Grebenc DW, Shah PY, McArthur OD, Dickson BH, Surette MG, Kim Y, Whitney JC (2022) Dual targeting factors are required for LXG toxin export by the bacterial type VIIb secretion system. mBio e02137-22.
Günther P*, Quentin D*, Ahmad S, Sachar K, Gatsogiannis C, Whitney JC#, Raunser S# (2022) Structure of a Bacterial Rhs effector exported by the type VI secretion system. PLoS Pathogens 18, e1010182. *Equal contribution. #co-corresponding authors.
Max Planck Institute of Molecular Physiology Press Release
2021
Chau NYE, Ahmad S, Whitney JC, Coombes BK (2021) Emerging and divergent roles of pyrophosphorylated nucleotides in bacterial physiology and pathogenesis. PLoS Pathogens 17, e1009532.
Steinchen W, Ahmad S, Valentini M, Eilers K, Majkini M, Altegoer F, Lechner M, Filloux A, Whitney JC, Bange G (2021) Dual role of a (p)ppGpp- and (p)ppApp-degrading enzyme in biofilm formation and interbacterial antagonism. Mol Microbiol 115, 1339-1356.
Tran HR*, Grebenc DW*, Klein TA, Whitney JC (2021) Bacterial type VII secretion: an important player in host-microbe and microbe-microbe interactions. Mol Microbiol 115, 478-489. *Equal contribution.
Klein TA, Grebenc DW, Gandhi SY, Shah VS, Kim Y and Whitney JC (2021) Structure of the extracellular region of the bacterial type VIIb secretion system subunit EsaA. Structure 29, 177-185.
2020
Ahmad S, Tsang KK, Sachar K, Quentin D, Tashin TM, Bullen NP, Raunser S, McArthur AG, Prehna G#, Whitney JC# (2020) Structural basis for effector transmembrane domain recognition by type VI secretion system chaperones. eLife 10.7554/eLife.62816. #co-corresponding authors.
Marmont LS, Whitfield GB, Pfoh R, Williams RJ, Randall TE, Ostaszewski A, Razvi E, Groves RA, Robinson H, Nitz M, Parsek MR, Lewis IA, Whitney JC, Harrison JJ and Howell PL (2020) PelX is a UDP-N-acetylglucosamine C4-epimerase involved in Pel polysaccharide-dependent biofilm formation. J Biol Chem 295:11949-62.
Klein TA*, Ahmad S* and Whitney JC (2020) Contact-dependent interbacterial antagonism mediated by protein secretion machines. Trends Microbiol 28, 387-400. *Equal contribution.
Whitfield GB, Marmont LS, Ostaszewski A, Rich JD, Whitney JC, Parsek MR, Harrison JJ and Howell PL (2020) Pel polysaccharide biosynthesis requires an inner membrane complex comprised of PelD, PelE, PelF and PelG. J Bacteriol 202, e00684-19.
2019
Ahmad S*, Wang B*, Walker MD, Tran HR, Stogios PJ, Savchenko A, Grant RA, McArthur AG, Laub MT# and Whitney JC# (2019) An interbacterial toxin inhibits target cell growth by synthesizing (p)ppApp. Nature 575, 674-678. *Equal contribution. #co-corresponding authors.
News & Views written by Anderson BW and Wang JD (2019) Toxin discovery reveals fresh ammunition for bacterial warfare. Nature 575, 599-600.
Featured on ASM’s weekly podcast This Week in Microbiology
Highlighted by Elio Schaechter for Small Things Considered
Written up in the Hamilton Spectator
Wood TE, Howard SA, Förster A, Nolan LM, Manoli E, Bullen NP, Yau HCL, Hachani A, Hayward RD, Whitney JC, Vollmer W, Freemont PS and Filloux A (2019) The Pseudomonas aeruginosa type VI secretion system delivers a periplasmic toxin that disrupts bacterial cell morphology. Cell Reports 29, 187-201.
2018
Klein TA, Pazos M, Surette MG, Vollmer W and Whitney JC (2018) Molecular basis for immunity protein recognition of a type VII secretion system exported antibacterial toxin. J Mol Biol 430, 4344-4358.
Quentin D, Ahmad S, Shanthamoorthy P, Mougous JD, Whitney JC# and Raunser S# (2018) Mechanism of loading and translocation of type VI secretion system effector Tse6. Nature Microbiol 3, 1142-1152. #co-corresponding authors.
Blair KM, Mears KS, Taylor JA, Fero J, Jones LA, Gafken PR, Whitney JC and Salama NR (2018) The Helicobacter pylori cell shape promoting protein Csd5 interacts with the cell wall, MurF, and the bacterial cytoskeleton. Mol Microbiol 110, 114-127.
Tang JY*, Bullen NP*, Ahmad S* and Whitney JC (2018) Diverse NADase effector families mediate interbacterial antagonism via the type VI secretion system. J Biol Chem 293, 1504-1514. *Equal contribution.
Editors’ Pick Highlight written by Lopez J and Feldman MF (2018) Expanding the molecular weaponry of bacterial species. J Biol Chem 293, 1515-1516.
2017
Marmont LS, Whitfield GB, Rich JD, Yip P, Giesbrecht LB, Stremick CA, Whitney JC, Parsek MR, Harrison JJ and Howell PL (2017) PelA and PelB proteins form a modification and secretion complex essential for Pel polysaccharide-dependent biofilm formation in Pseudomonas aeruginosa. J Biol Chem 292, 19411-19422.
Whitney JC, Peterson SB, Kim J, Pazos M, Verster AJ, Radey MC, Kulasekara HD, Ching MQ, Bullen NP, Bryant D, Goo YA, Surette MG, Borenstein E, Vollmer W and Mougous JD (2017) A broadly distributed toxin family mediates contact-dependent antagonism between Gram-positive bacteria. eLife 10.7554/eLife.26938.
Marmont LS, Rich JD, Whitney JC, Whitfield GB, Almblad H, Robinson H, Parsek MR, Harrison JJ and Howell PL (2017) Oligomeric lipoprotein PelC guides Pel polysaccharide export across the outer membrane of Pseudomonas aeruginosa. Proc Natl Acad Sci USA 114, 2892-2897.
2016
Eshraghi A, Kim J, Walls AC, Ledvina HE, Miller CN, Ramsey KM, Whitney JC, Radey MC, Peterson SB, Ruhland BR, Tran BQ, Goo YA, Goodlett DR, Dove SL, Celli J, Veesler D and Mougous JD (2016) Secreted Effectors Encoded within and outside of the Francisella Pathogenicity Island Promote Intramacrophage Growth. Cell Host Microbe 5, 573-583.
Wexler AG, Bao Y, Whitney JC, Bobay LM, Schofield WB, Barry NA, Russell AB, Tran BQ, Goo YA, Goodlett DR, Ochman H, Mougous JD and Goodman AL (2016) Human symbionts continuously inject and neutralize antibacterial toxins to persist in the gut. Proc Natl Acad Sci USA 113, 3639-3644.
2015
Whitney JC, Quentin D, Sawai S, LeRoux M, Harding BN, Ledvina HE, Tran BQ, Robinson H, Goo YA, Goodlett DR, Raunser S, Mougous JD (2015) An interbacterial NAD(P)+ glycohydrolase toxin requires elongation factor Tu for delivery to target cells. Cell 163, 607-619.
Preview written by Cabeen MT and Losick R (2015) Bacterial Backstabbing: EF-Tu, Brute? Cell 163, 537-539.
Whitney JC*, Whitfield GB*, Marmont LS, Yip P, Neculai AM, Lobsanov YD, Robinson H, Ohman DE, Howell PL (2015) Dimeric c-di-GMP is required for post-translational regulation of alginate production in Pseudomonas aeruginosa. J Biol Chem 290, 12451- 12462. *Equal contribution
LeRoux M, Kirkpatrick RL, Montauti EI, Tran BQ, Peterson SB, Harding BN, Whitney JC, Russell AB, Traxler B, Goo YA, Goodlett DR, Wiggins PA, Mougous JD (2015) Kin cell lysis is a danger signal that activates antibacterial pathways of Pseudomonas aeruginosa. eLife 10.7554/eLife.05701.
2014
Baker P, Ricer T, Moynihan PJ, Kitova EN, Walvoort MT, Little DJ, Whitney JC, Dawson K, Weadge JT, Robinson H, Ohman DE, Codée JD, Klassen JS, Clarke AJ, Howell PL (2014) Pseudomonas aeruginosa SGNH hydrolase-like proteins AlgJ and AlgX have similar topology but separate and distinct roles in alginate acetylation. PLoS Pathog 10, e1004334.
Tan J, Rouse SL, Li D, Pye VE, Vogeley L, Brinth AR, El Arnaout T, Whitney JC, Howell PL, Sansom MS, Caffrey M (2014) A conformational landscape for alginate secretion across the outer membrane of Pseudomonas aeruginosa. Acta Crystallogr Sect D: Biol Crystallogr 70(Pt 8), 2054-2068.
Russell AB, Wexler AG, Harding BN, Whitney JC, Bohn AJ, Goo YA, Tran BQ, Barry NA, Zheng H, Peterson SB, Chou S, Gonen T, Goodlett DR, Goodman AL, Mougous JD (2014) A type VI secretion-related pathway in Bacteroidetes mediates interbacterial antagonism. Cell Host Microbe 16, 227-236.
Whitney JC, Beck CM, Goo YA, Russell AB, Harding BN, De Leon JA, Cunningham DA, Tran BQ, Low DA, Goodlett DR, Hayes CS, Mougous JD (2014) Genetically distinct pathways guide effector export through the type VI secretion system. Mol Microbiol 92, 529-542. (Highlighted as one of the 30 most influential papers published in Molecular Microbiology over the last 30 years)
2013
Whitney JC, Chou S, Russell AB, Biboy J, Gardiner TE, Ferrin MA, Brittnacher M, Vollmer W, Mougous JD (2013) Identification, structure and function of a novel type VI secretion peptidoglycan glycoside hydrolase effector–immunity pair. J Biol Chem 288, 26616-26624.
Ali SS, Whitney JC, Stevenson J, Robinson H, Howell PL, Navarre WW (2013) Structural insights into the regulation of foreign genes in Salmonella by the Hha/H-NS complex. J Biol Chem 288, 13356-13369.
Colvin KM, Alnabelseya N, Baker P, Whitney JC, Howell PL, Parsek MR (2013) PelA deacetylase activity is required for Pel polysaccharide synthesis in Pseudomonas aeruginosa. J Bacteriol 195, 2329-2339.
Whitney JC, Howell PL (2013) Synthase-dependent exopolysaccharide secretion in Gram-negative bacteria. Trends Microbiol 21, 63-72. (Featured on cover of journal, recommended by Faculty of 1000)
2012
Guo S, Garnham CP, Whitney JC, Graham LA, Davies PL (2012) Re-evaluation of a bacterial antifreeze protein as an adhesin with ice-binding activity. PLoS One 7, e48805.
Little DJ, Poloczek J, Whitney JC, Robinson H, Yip P, Nitz M, Howell PL (2012) The structure and metal dependent activity of Escherichia coli PgaB provides insight into the partial de-N-acetylation of poly-β-1,6-N-acetyl-D-glucosamine. J Biol Chem 287, 31126-31137.
Little DJ, Whitney JC, Robinson H, Yip P, Nitz M, Howell PL (2012) Crystallization and preliminary X-ray analysis of Escherichia coli PgaB using in situ proteolysis and mass spectrometry. Acta Crystallogr Sect F: Struct Biol Cryst Commun 68(Pt 7), 842-845.
Whitney JC, Colvin KM, Marmont LS, Robinson H, Parsek MR, Howell PL (2012) Structure of the cytoplasmic region of PelD, a degenerate diguanylate cyclase receptor that regulates PEL polysaccharide production in Pseudomonas aeruginosa. J Biol Chem 287, 23582-23593.
Marmont LS, Whitney JC, Robinson H, Colvin KM, Parsek MR, Howell PL (2012) Expression, purification, crystallization and preliminary X-ray analysis of Pseudomonas aeruginosa PelD. Acta Crystallogr Sect F: Struct Biol Cryst Commun 68(Pt 2), 181-184.
Colvin KM, Irie Y, Tart CS, Urbano R, Whitney JC, Ryder C, Howell PL, Wozniak DJ, Parsek MR (2012) The PEL and PSL polysaccharides provide Pseudomonas aeruginosa structural redundancy within the biofilm matrix. Environ Microbiol 14, 1913-1928.
2008-2011
Whitney JC, Hay ID, Li C, Eckford PD, Robinson H, Amaya MF, Wood LF, Ohman DE, Bear CE, Rehm BH, Howell PL (2011) Structural basis for alginate secretion across the bacterial outer membrane. Proc Natl Acad Sci USA 108, 13083-13088.
Keiski CL, Harwich M, Jain S, Neculai AM, Yip P, Robinson H, Whitney JC, Riley L, Burrows LL, Ohman DE, Howell PL (2010) AlgK is a TPR-containing protein and the periplasmic component of a novel exopolysaccharide secretin. Structure 18, 265-273.
Whitney JC, Neculai AM, Ohman DE, Howell PL (2009) Expression, refolding, crystallization and preliminary X-ray analysis of Pseudomonas aeruginosa AlgE. Acta Crystallogr Sect F: Struct Biol Cryst Commun 65(Pt 5), 463-466.
Le Marquand P, Tsui GC, Whitney JC, Tam W (2008) Iron-catalyzed cross-coupling reactions between a bicyclic alkenyl triflate and Grignard reagents. J Org Chem 73, 7829-7832